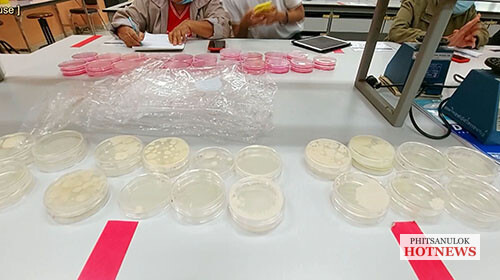

เมื่อวันที่ 14 พ.ย.63 ที่อาคารคณะวิทยาศาสตร์การแพทย์ มหาวิทยาลัยนเรศวร ศาสตราจารย์พิเศษ ดร. กาญจนา เงารังษี อธิการบดี มหาวิทยาลัยนเรศวรพิษณุโลก และ นางจินตนา จันทร์บำรุง หัวหน้าผู้ตรวจราชการกระทรวงการพัฒนาสังคมและความมั่นคงของมนุษย์(พม.) และคณะ ร่วมด้วย ดร.วรเดช ณ กลม ผู้ช่วยอธิการบดี รศ.ดร.สุขกิจ ยะโสธรศรีกุล คณบดีคณะวิทยาศาสตร์การแพทย์ มหาวิทยาลัยนเรศวร
การตรวจเยี่ยมติดตามการอบรมเชิงปฏิบัติการยกระดับพัฒนาคุณภาพมาตรฐานผลิตอาหาร (น้ำพริก) ตามโครงการพัฒนาหลักสูตรสร้างอาชีพกลุ่มสตรีและครอบครัวเพื่อฟื้นฟูยกระดับอาชีพหลังวิกฤตโควิด-19 โดยความร่วมมือข้อตกลงระหว่างกระทรวงการพัฒนาสังคมและความมั่นคงของมนุษย์ กับมหาวิทยาลัยนเรศวร โดยมีสตรีผู้เข้าร่วมอบรม ประกอบด้วย จังหวัดพิษณุโลก พิจิตร สุโขทัย ลำปาง จำนวน 30 คน ระยะเวลา 5 วัน โดยไม่เสียค่าใช้จ่ายแต่อย่างใด
ทั้งนี้ เป็นการยกระดับคุณภาพของผลิตภัณฑ์ โดยการใช้หลักการของอาหารปลอดภัยและอาหารปลอดเชื้อโรค มาสร้างมาตรฐาน และต่อยอดไปสู่การค้าบนตลาดออนไลน์ โดยภายใต้กิจกรรมนี้จะมีการตรวจสอบเชื้อจุลินทรีย์ของผลิตภัณฑ์น้ำพริก เพื่อให้มั่นใจได้ว่าผลิตภัณฑ์มีความปลอดภัย และมีการพัฒนาการน้ำพริก ที่มีคุณภาพผ่านระบบการตรวจสอบของหน่วยงาน สามารถส่งไปจำหน่ายได้ทั้งในประเทศและต่างประเทศ